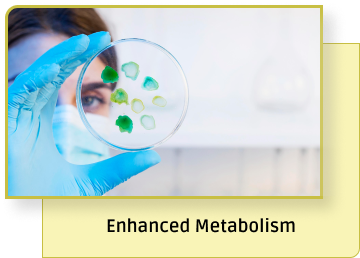
Banner Carousel

Two Phase Media Format
Enable-NK™ Duo is a set of two cell culture media, consisting of Enable-NK™ Grow and Enable-NK™ Activate formulated specifically for human natural killer (NK) cells. Developed under the aegis of an NIH grant, it is the world’s first phytochemicals-centric cell-culture media formulation which incorporates USP compendial-grade plant extracts.
Enable-NK™ Duo consists of two different formulations, each with a specific purpose.